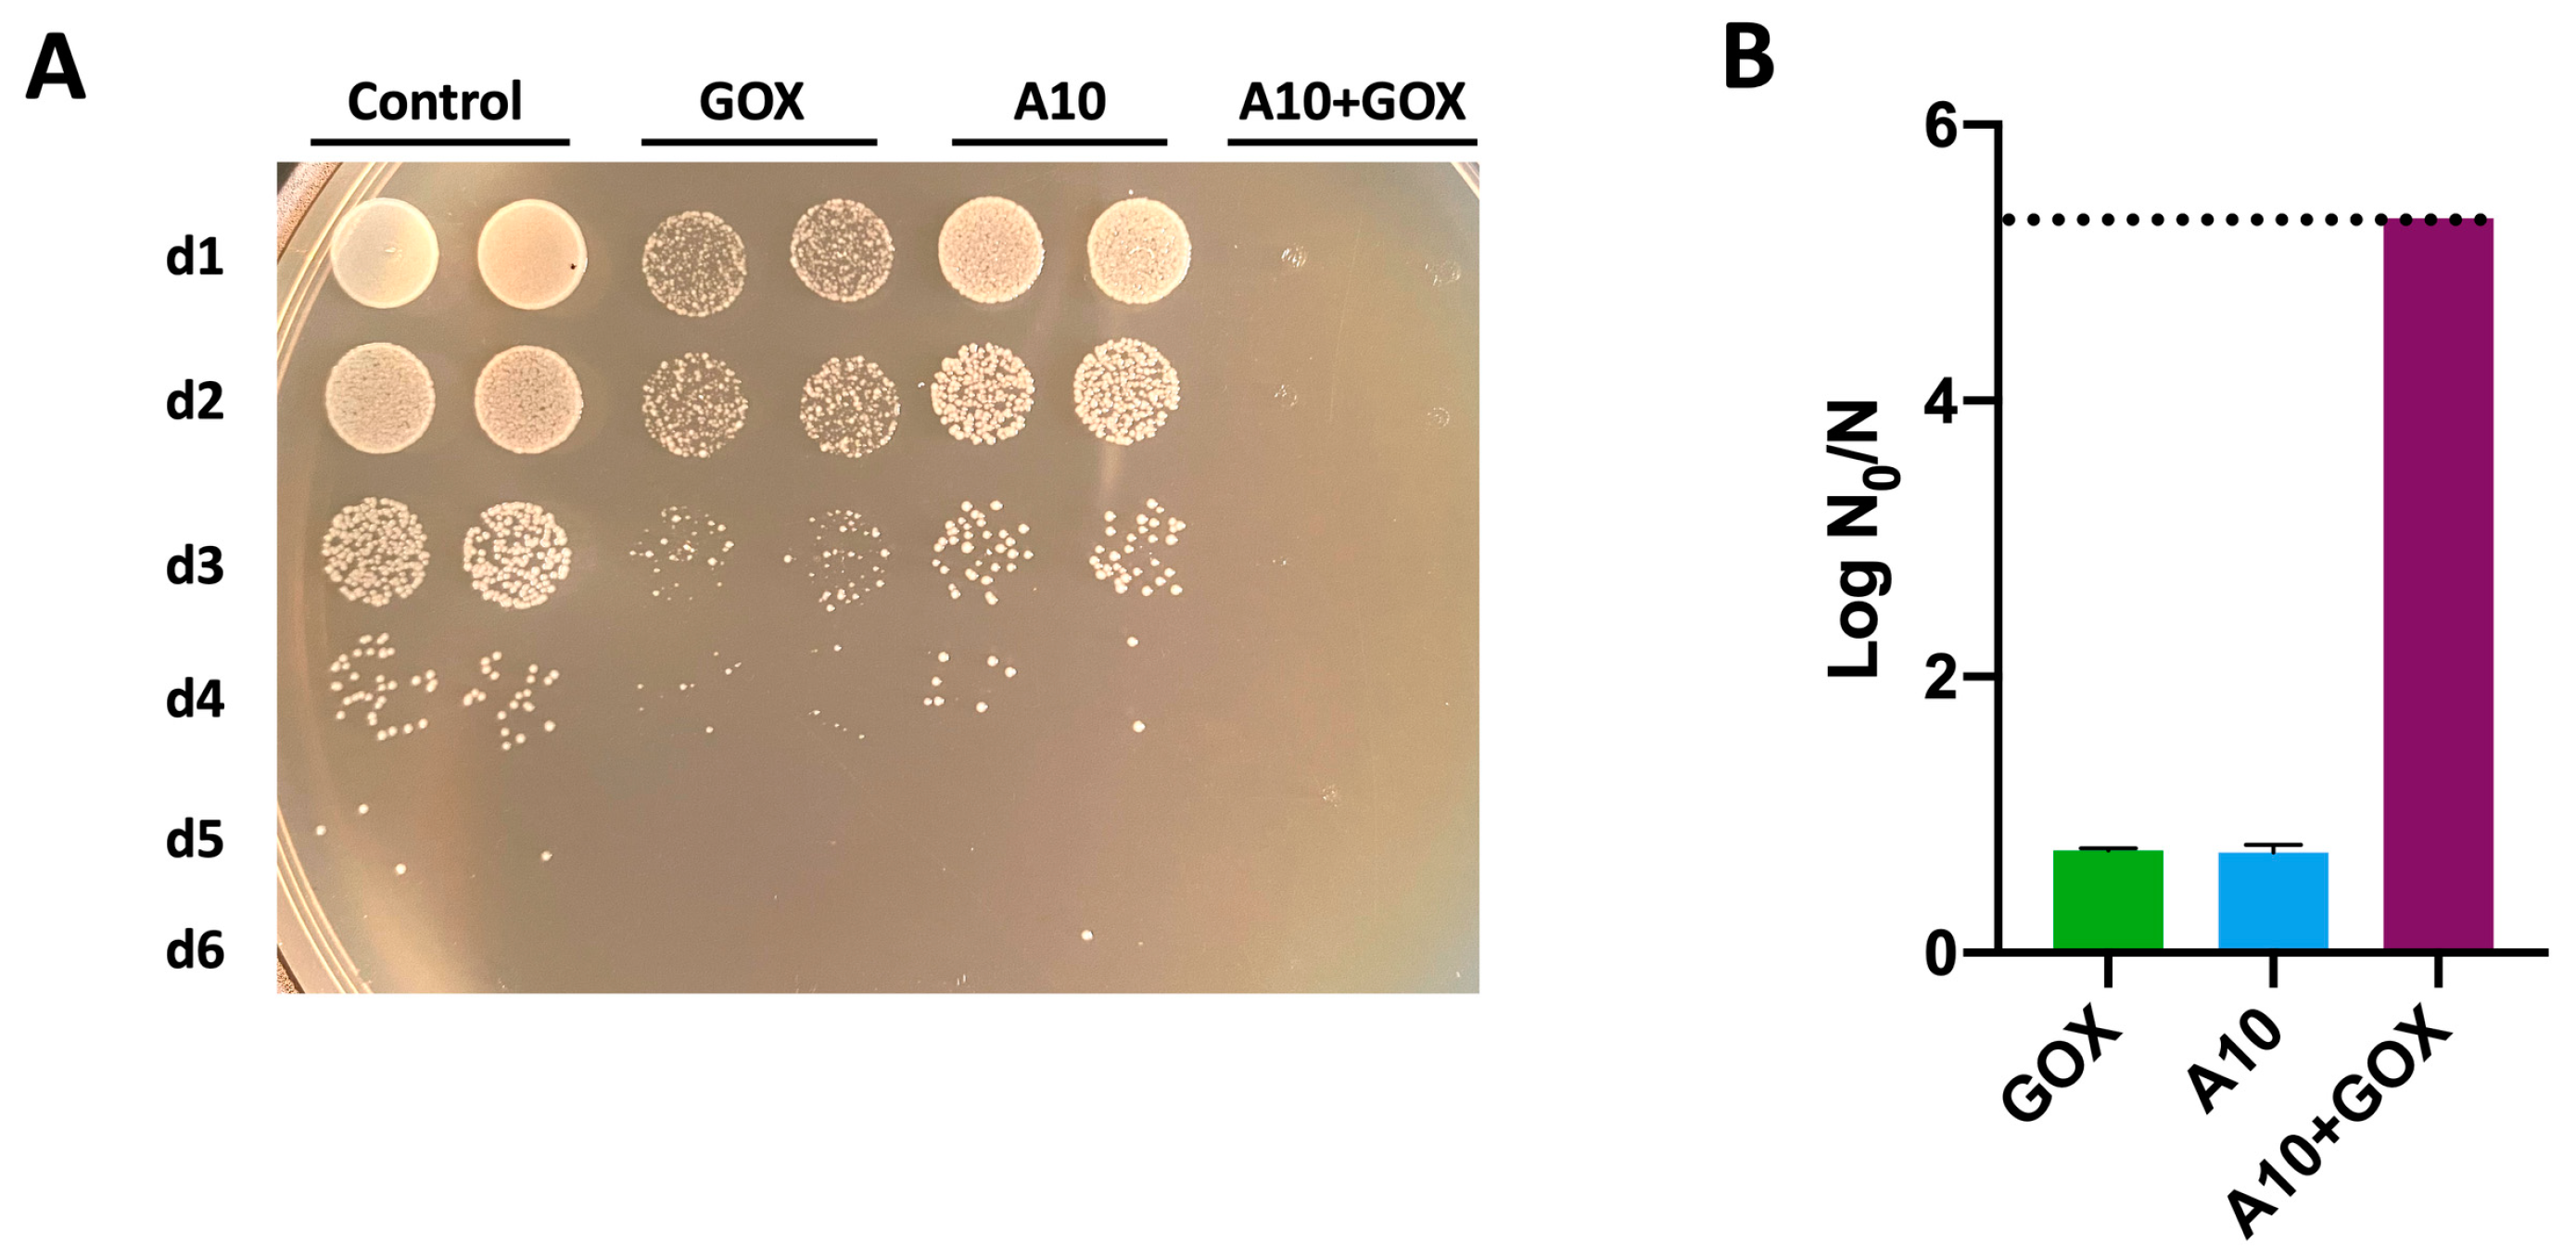
Biomolecules 15 00024 g007

Synergistic Enzybiotic Effect of a Bacteriophage Endolysin and an Engineered Glucose Oxidase Against Listeria
Abstract
1. Introduction
2. Materials and Methods
2.1. Enzyme Production and Quantification
2.2. Antibacterial Assays
2.3. Flow Cytometry
2.4. Microscopy Analysis
2.5. Statistical Analysis
3. Results and Discussion
3.1. Analysis of the Protein Structure of A10 Endolysin

3.2. Dose–Response Analysis of Endolysin A10 and GOX Against Listeria Innocua
3.3. Synergistic Biocidal Effect of Endolysin A10 and GOX Against Listeria Innocua
3.4. Flow Cytometry Analysis of Endolysin A10 and GOX Against Listeria Innocua
3.5. Microscopy Analysis of Endolysin A10 and GOX Against Listeria Innocua
3.6. Synergistic Biocidal Effect of Endolysin A10 and GOX Against Listeria monocytogenes
4. Conclusions
Supplementary Materials
Author Contributions
Funding
Institutional Review Board Statement
Informed Consent Statement
Data Availability Statement
Acknowledgments
Conflicts of Interest
References
- Tuytschaever, T.; Raes, K.; Sampers, I. Listeria monocytogenes in Food Businesses: From Persistence Strategies to Intervention/Prevention Strategies—A Review. Compr. Rev. Food Sci. Food Saf. 2023, 22, 3910–3950. [Google Scholar] [CrossRef]
- Milillo, S.R.; Friedly, E.C.; Saldivar, J.C.; Muthaiyan, A.; O’Bryan, C.; Crandall, P.G.; Johnson, M.G.; Ricke, S.C. A Review of the Ecology, Genomics, and Stress Response of Listeria innocua and Listeria monocytogenes. Crit. Rev. Food Sci. Nutr. 2012, 52, 712–725. [Google Scholar] [CrossRef] [PubMed]
- Lakicevic, B.; Jankovic, V.; Pietzka, A.; Ruppitsch, W. Wholegenome Sequencing as the Gold Standard Approach for Control of Listeria monocytogenes in the Food Chain. J. Food Prot. 2023, 26, 100003. [Google Scholar] [CrossRef]
- Lianou, A.; Sofos, J.N. A Review of the Incidence and Transmission of Listeria monocytogenes in Ready-to-Eat Products in Retail and Food Service Environments. J. Food Prot. 2007, 70, 2172–2198. [Google Scholar] [CrossRef] [PubMed]
- Gonzales-Barron, U.; Cadavez, V.; Mota, J.D.O.; Guillier, L.; Sanaa, M. A Critical Review of Risk Assessment Models for Listeria monocytogenes in Meat and Meat Products. Foods 2024, 13, 359. [Google Scholar] [CrossRef] [PubMed]
- Sedlak, D.L.; von Gunten, U. The Chlorine Dilemma. Science 2011, 331, 42–43. [Google Scholar] [CrossRef] [PubMed]
- Liu, W.-R.; Yang, Y.-Y.; Liu, Y.-S.; Zhao, J.-L.; Zhang, Q.-Q.; Yao, L.; Zhang, M.; Jiang, Y.-X.; Wei, X.-D.; Ying, G.-G. Biocides in the River System of a Highly Urbanized Region: A Systematic Investigation Involving Runoff Input. Sci. Total Environ. 2018, 624, 1023–1030. [Google Scholar] [CrossRef]
- Hernández-Moreno, D.; Blázquez, M.; Andreu-Sánchez, O.; Bermejo-Nogales, A.; Fernández-Cruz, M.L. Acute Hazard of Biocides for the Aquatic Environmental Compartment from a Life-Cycle Perspective. Sci. Total Environ. 2019, 658, 416–423. [Google Scholar] [CrossRef] [PubMed]
- Fairchild, T.M.; Foegeding, P.M. A Proposed Nonpathogenic Biological Indicator for Thermal Inactivation of Listeria monocytogenes. Appl. Environ. Microbiol. 1993, 59, 1247–1250. [Google Scholar] [CrossRef]
- Zhang, G.; Ma, L.; Oyarzabal, O.A.; Doyle, M.P. Aerosol Studies with Listeria innocua and Listeria monocytogenes. J. Food Prot. 2007, 70, 1857–1865. [Google Scholar] [CrossRef]
- Milly, P.; Toledo, R.; Chen, J. Evaluation of Liquid Smoke Treated Ready-to-Eat (RTE) Meat Products for Control of Listeria innocua M1. J. Food Sci. 2008, 73, M179–M183. [Google Scholar] [CrossRef] [PubMed]
- Glaser, P.; Frangeul, L.; Buchrieser, C.; Rusniok, C.; Amend, A.; Baquero, F.; Berche, P.; Bloecker, H.; Brandt, P.; Chakraborty, T.; et al. Comparative Genomics of Listeria Species. Science 2001, 294, 849–852. [Google Scholar] [CrossRef] [PubMed]
- Rahman, M.U.; Wang, W.; Sun, Q.; Shah, J.A.; Li, C.; Sun, Y.; Li, Y.; Zhang, B.; Chen, W.; Wang, S. Endolysin, a Promising Solution against Antimicrobial Resistance. Antibiotics 2021, 10, 1277. [Google Scholar] [CrossRef] [PubMed]
- Broendum, S.S.; Buckle, A.M.; McGowan, S. Catalytic Diversity and Cell Wall Binding Repeats in the Phage-Encoded Endolysins. Mol. Microbiol. 2018, 110, 879–896. [Google Scholar] [CrossRef]
- Schmelcher, M.; Donovan, D.M.; Loessner, M.J. Bacteriophage Endolysins as Novel Antimicrobials. Future Microbiol. 2012, 7, 1147–1171. [Google Scholar] [CrossRef] [PubMed]
- Vázquez, R.; García, E.; García, P. Sequence-Function Relationships in Phage-Encoded Bacterial Cell Lytic Enzymes and Their Implications for Phage-Derived Product Design. J. Virol. 2021, 95, 1–23. [Google Scholar] [CrossRef] [PubMed]
- Khan, F.M.; Chen, J.-H.; Zhang, R.; Liu, B. A Comprehensive Review of the Applications of Bacteriophage-Derived Endolysins for Foodborne Bacterial Pathogens and Food Safety: Recent Advances, Challenges, and Future Perspective. Front. Microbiol. 2023, 14, 1259210. [Google Scholar] [CrossRef]
- Lee, C.; Kim, H.; Ryu, S. Bacteriophage and Endolysin Engineering for Biocontrol of Food Pathogens/Pathogens in the Food: Recent Advances and Future Trends. Crit. Rev. Food Sci. Nutr. 2023, 63, 8919–8938. [Google Scholar] [CrossRef]
- Nazir, A.; Xu, X.; Liu, Y.; Chen, Y. Phage Endolysins: Advances in the World of Food Safety. Cells 2023, 12, 2169. [Google Scholar] [CrossRef]
- Pennone, V.; Sanz-Gaitero, M.; O’connor, P.; Coffey, A.; Jordan, K.; van Raaij, M.J.; McAuliffe, O. Inhibition of L. monocytogenes Biofilm Formation by the Amidase Domain of the Phage Vb_lmos_293 Endolysin. Viruses 2019, 11, 722. [Google Scholar] [CrossRef]
- Romero, P.; Bartual, S.G.; Schmelcher, M.; Glück, C.; Hermoso, J.A.; Loessner, M.J. Structural Insights into the Binding and Catalytic Mechanisms of the Listeria monocytogenes Bacteriophage Glycosyl Hydrolase PlyP40. Mol. Microbiol. 2018, 108, 128–142. [Google Scholar] [CrossRef] [PubMed]
- van Nassau, T.J.; Lenz, C.A.; Scherzinger, A.S.; Vogel, R.F. Combination of Endolysins and High Pressure to Inactivate Listeria monocytogenes. Food Microbiol. 2017, 68, 81–88. [Google Scholar] [CrossRef] [PubMed]
- Zhang, H.; Bao, H.; Billington, C.; Hudson, J.A.; Wang, R. Isolation and Lytic Activity of the Listeria Bacteriophage Endolysin LysZ5 against Listeria monocytogenes in Soya Milk. Food Microbiol. 2012, 31, 133–136. [Google Scholar] [CrossRef] [PubMed]
- Kawai, Y.; Mercier, R.; Mickiewicz, K.; Serafini, A.; de Carvalho, L.P.S.; Errington, J. Crucial Role for Central Carbon Metabolism in the Bacterial L-Form Switch and Killing by β-Lactam Antibiotics. Nat. Microbiol. 2019, 4, 1716–1726. [Google Scholar] [CrossRef] [PubMed]
- Wohlfarth, J.C.; Feldmüller, M.; Schneller, A.; Kilcher, S.; Burkolter, M.; Meile, S.; Pilhofer, M.; Schuppler, M.; Loessner, M.J. L-Form Conversion in Gram-Positive Bacteria Enables Escape from Phage Infection. Nat. Microbiol. 2023, 8, 387–399. [Google Scholar] [CrossRef]
- Studer, P.; Staubli, T.; Wieser, N.; Wolf, P.; Schuppler, M.; Loessner, M.J. Proliferation of Listeria monocytogenes L-Form Cells by Formation of Internal and External Vesicles. Nat. Commun. 2016, 7, 13631. [Google Scholar] [CrossRef] [PubMed]
- Bauer, J.A.; Zámocká, M.; Majtán, J.; Bauerová-Hlinková, V. Glucose Oxidase, an Enzyme “Ferrari”: Its Structure, Function, Production and Properties in the Light of Various Industrial and Biotechnological Applications. Biomolecules 2022, 12, 472. [Google Scholar] [CrossRef] [PubMed]
- Talens-Perales, D.; Nicolau-Sanus, M.; Marín-Navarro, J.; Polaina, J.; Daròs, J.-A. Production in Nicotiana benthamiana of a Thermotolerant Glucose Oxidase That Shows Enzybiotic Activity against Escherichia coli and Staphylococcus aureus. Curr. Res. Biotechnol. 2023, 6, 100148. [Google Scholar] [CrossRef]
- Califano, D.; Patenall, B.L.; Kadowaki, M.A.; Mattia, D.; Scott, J.L.; Edler, K.J. Enzyme-Functionalized Cellulose Beads as a Promising Antimicrobial Material. Biomacromolecules 2021, 22, 754–762. [Google Scholar] [CrossRef] [PubMed]
- Marín-Navarro, J.; Roupain, N.; Talens-Perales, D.; Polaina, J. Identification and Structural Analysis of Amino Acid Substitutions That Increase the Stability and Activity of Aspergillus niger Glucose Oxidase. PLoS ONE 2015, 10, e0144289. [Google Scholar] [CrossRef] [PubMed]
- Falcioni, T.; Papa, S.; Gasol, J.M. Evaluating the Flow-Cytometric Nucleic Acid Double-Staining Protocol in Realistic Situations of Planktonic Bacterial Death. Appl. Environ. Microbiol. 2008, 74, 1767–1779. [Google Scholar] [CrossRef] [PubMed]
- Nescerecka, A.; Hammes, F.; Juhna, T. A Pipeline for Developing and Testing Staining Protocols for Flow Cytometry, Demonstrated with SYBR Green I and Propidium Iodide Viability Staining. J. Microbiol. Methods 2016, 131, 172–180. [Google Scholar] [CrossRef] [PubMed]
- Schindelin, J.; Arganda-Carreras, I.; Frise, E.; Kaynig, V.; Longair, M.; Pietzsch, T.; Preibisch, S.; Rueden, C.; Saalfeld, S.; Schmid, B.; et al. Fiji: An Open-Source Platform for Biological-Image Analysis. Nat. Methods 2012, 9, 676–682. [Google Scholar] [CrossRef]
- R Core Team. R: A Language and Environment for Statistical Computing; R Foundation for Statistical Computing: Vienna, Austria, 2021; Available online: https://www.R-project.org/ (accessed on 12 December 2024).
- Low, L.Y.; Yang, C.; Perego, M.; Osterman, A.; Liddington, R. Role of Net Charge on Catalytic Domain and Influence of Cell Wall Binding Domain on Bactericidal Activity, Specificity, and Host Range of Phage Lysins. J. Biol. Chem. 2011, 286, 34391–34403. [Google Scholar] [CrossRef] [PubMed]
- Korndörfer, I.P.; Danzer, J.; Schmelcher, M.; Zimmer, M.; Skerra, A.; Loessner, M.J. The Crystal Structure of the Bacteriophage PSA Endolysin Reveals a Unique Fold Responsible for Specific Recognition of Listeria Cell Walls. J. Mol. Biol. 2006, 364, 678–689. [Google Scholar] [CrossRef]
- Shen, Y.; Kalograiaki, I.; Prunotto, A.; Dunne, M.; Boulos, S.; Taylor, N.M.I.; Sumrall, E.T.; Eugster, M.R.; Martin, R.; Julian-Rodero, A.; et al. Structural Basis for Recognition of Bacterial Cell Wall Teichoic Acid by Pseudo-Symmetric SH3b-like Repeats of a Viral Peptidoglycan Hydrolase. Chem. Sci. 2021, 12, 576–589. [Google Scholar] [CrossRef] [PubMed]
- Waterhouse, A.; Bertoni, M.; Bienert, S.; Studer, G.; Tauriello, G.; Gumienny, R.; Heer, F.T.; De Beer, T.A.P.; Rempfer, C.; Bordoli, L.; et al. SWISS-MODEL: Homology Modelling of Protein Structures and Complexes. Nucleic Acids Res. 2018, 46, W296–W303. [Google Scholar] [CrossRef]
- Cao, R.; Wan, Q.; Xu, X.; Tian, S.; Wu, G.; Wang, J.; Huang, T.; Wen, G. Differentiation of DNA or Membrane Damage of the Cells in Disinfection by Flow Cytometry. J. Hazard. Mater. 2022, 435, 128924. [Google Scholar] [CrossRef] [PubMed]
- Cheng, S.; Cai, M.-H.; Wu, Y.-P.; Li, Y.; Wu, J.-C.; Li, A.-M.; Li, W.-T. Applying UV Absorbance and Fluorescence Indices to Estimate Inactivation of Bacteria and Formation of Bromate during Ozonation of Water and Wastewater Effluent. Water Res. 2018, 145, 354–364. [Google Scholar] [CrossRef]
- Wu, J.; Cheng, S.; Duan, Y.-Z.; Shen, S.-Q.; Jiang, B.-C.; Li, Y.; Shi, P.; Li, W.-T.; Zhang, Q.-X.; Li, A.-M. Kinetics and Efficacy of Membrane/DNA Damage to Bacillus subtilis and Autochthonous Bacteria during UV/Chlorine Treatment under Different pH and Irradiation Wavelengths. Chem. Eng. J. 2021, 422, 129885. [Google Scholar] [CrossRef]
- Herth, W.; Schnepf, E. The Fluorochrome, Calcofluor White, Binds Oriented to Structural Polysaccharide Fibrils. Protoplasma 1980, 105, 129–133. [Google Scholar] [CrossRef]
- Mason, D.; Lopéz-Amorós, R.; Allman, R.; Stark, J.; Lloyd, D. The Ability of Membrane Potential Dyes and Calcafluor White to Distinguish between Viable and Non-Viable Bacteria. J. Appl. Bacteriol. 1995, 78, 3–15. [Google Scholar] [CrossRef]
- Perrine-Walker, F.; Payne, J. Rapid Screening Method of Saccharomyces cerevisiae Mutants Using Calcofluor White and Aniline Blue. Braz. J. Microbiol. 2021, 52, 1077–1086. [Google Scholar] [CrossRef]
- Wood, P.J.; Fulcher, R.G. Dye interactions. A Basis for Specific Detection and Histochemistry of Polysaccharides. J. Histochem. Cytochem. 1983, 31, 823–826. [Google Scholar] [CrossRef] [PubMed]
- Vázquez, R.; Seoane-Blanco, M.; Rivero-Buceta, V.; Ruiz, S.; van Raaij, M.J.; García, P. Monomodular Pseudomonas aeruginosa Phage JG004 Lysozyme (Pae87) Contains a Bacterial Surface-Active Antimicrobial Peptide-like Region and a Possible Substrate-Binding Subdomain. Acta Crystallogr. D Struct. Biol. 2022, 78, 435–454. [Google Scholar] [CrossRef]
- Vilcacundo, R.; Méndez, P.; Reyes, W.; Romero, H.; Pinto, A.; Carrillo, W. Antibacterial Activity of Hen Egg White Lysozyme Denatured by Thermal and Chemical Treatments. Sci. Pharm. 2018, 86, 48. [Google Scholar] [CrossRef] [PubMed]
- Das, T.; Sehar, S.; Manefield, M. The Roles of Extracellular DNA in the Structural Integrity of Extracellular Polymeric Substance and Bacterial Biofilm Development. Environ. Microbiol. Rep. 2013, 5, 778–786. [Google Scholar] [CrossRef]
- Byun, K.-H.; Han, S.H.; Choi, M.W.; Kim, B.-H.; Ha, S.-D. Do Efficacy of Disinfectant and Bacteriophage Mixture against Planktonic and Biofilm State of Listeria monocytogenes to Control in the Food Industry. Int. J. Food Microbiol. 2024, 413, 110587. [Google Scholar] [CrossRef]
- Dominguez, L.; Garayazabal, J.F.F.; Ferri, E.R.; Vazquez, J.A.; Gomez-Lucia, E.; Ambrosio, C.; Suarez, G. Viability of Listeria monocytogenes in Milk Treated with Hydrogen Peroxide. J. Food Prot. 1987, 50, 636–639. [Google Scholar] [CrossRef]
- Fisher, C.W.; Lee, D.; Dodge, B.-A.; Hamman, K.M.; Robbins, J.B.; Martin, S.E. Influence of Catalase and Superoxide Dismutase on Ozone Inactivation of Listeria monocytogenes. Appl. Environ. Microbiol. 2000, 66, 1405–1409. [Google Scholar] [CrossRef]

Disclaimer/Publisher’s Note: The statements, opinions and data contained in all publications are solely those of the individual author(s) and contributor(s) and not of MDPI and/or the editor(s). MDPI and/or the editor(s) disclaim responsibility for any injury to people or property resulting from any ideas, methods, instructions or products referred to in the content. |
© 2024 by the authors. Licensee MDPI, Basel, Switzerland. This article is an open access article distributed under the terms and conditions of the Creative Commons Attribution (CC BY) license (https://creativecommons.org/licenses/by/4.0/).
Share and Cite
Talens-Perales, D.; Daròs, J.-A.; Polaina, J.; Marín-Navarro, J. Synergistic Enzybiotic Effect of a Bacteriophage Endolysin and an Engineered Glucose Oxidase Against Listeria. Biomolecules 2025, 15, 24. https://doi.org/10.3390/biom15010024
Talens-Perales D, Daròs J-A, Polaina J, Marín-Navarro J. Synergistic Enzybiotic Effect of a Bacteriophage Endolysin and an Engineered Glucose Oxidase Against Listeria. Biomolecules. 2025; 15(1):24. https://doi.org/10.3390/biom15010024
Chicago/Turabian StyleTalens-Perales, David, José-Antonio Daròs, Julio Polaina, and Julia Marín-Navarro. 2025. "Synergistic Enzybiotic Effect of a Bacteriophage Endolysin and an Engineered Glucose Oxidase Against Listeria" Biomolecules 15, no. 1: 24. https://doi.org/10.3390/biom15010024
APA StyleTalens-Perales, D., Daròs, J.-A., Polaina, J., & Marín-Navarro, J. (2025). Synergistic Enzybiotic Effect of a Bacteriophage Endolysin and an Engineered Glucose Oxidase Against Listeria. Biomolecules, 15(1), 24. https://doi.org/10.3390/biom15010024

